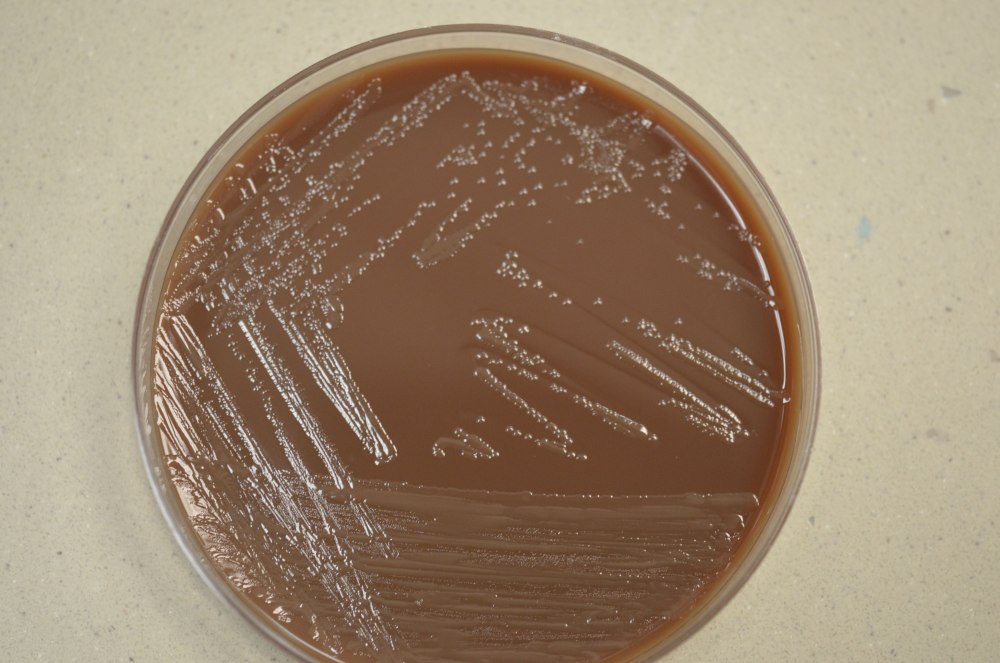

Бактерии гемофильная палочка

---

Микробы вызывающие отит

Haemophilus influenzae пневмония

Агалактийный стрептококк

Bacillus subtilis

Бактерии Haemophilus influenzae

Шоколадный агар (h. influenza

Haemophilus influenzae на шоколадном агаре

Гемофилез возбудитель

Бактериальная дизентерия шигеллез

Гемофильная палочка микроскопия


Бордетеллы коклюша микроскопия

Бактерии микробиота кишечника

Гемофильная палочка микроскопия

Гемофилы на кровяном агаре

Haemophilus influenzae аэроб


Гемофильная палочка (h. influenzae);

Печень при геморрагической лихорадке

Алкалофильные бактерии

Микобактерия туберкулеза палочка Коха

Гемофильная пневмония

Коклюш бактерия

Бактерии Haemophilus influenzae


Бактерии Haemophilus influenzae

Гемофильная палочка Афанасьева Пфейффера

Грамположительные микрококки

Гемофилы на кровяном агаре

Haemophilus influenzae питательные среды

Чашка Петри с агаром

Красивые микробы

Гемофильная инфекция фото

Гемофильная палочка микробиология

Гемофильная палочка микроскопия


Стрептококки форма бактерии

Listeria monocytogenes микробиология

Бактерии стрептококк мутанс

Гемофильный орбитальный целлюлит

Гемофильная палочка Пфайфера

Шоколадный агар (h. influenza

Гемофильная палочка Афанасьева Пфейффера

Коклюш Bordetella pertussis (бордетелла пертуссис)

Лактобактерии палочки Дедерлейна

Haemophilus influenzae (палочка Пфайфера)

Гемофильная палочка возбудитель

Lactobacillus rhamnosus

Коккобациллы микробиология

Палочка Коха (Mycobacterium tuberculosis)

Псевдомонада aeruginosa

Гемофильная палочка Афанасьева Пфейффера

Бактериальный уретрит

Haemophilus influenzae колонии

Гемофильная палочка патогенез

Actinobacillus actinomycetemcomitans

Стрептококк АПИС

Гемофильная инфекция

Бактерии редуценты

Бактерии Haemophilus influenzae

Палочковидные бактерии клебсиеллы

Гемофильная палочка (h. influenzae);

Гемофильная палочка микробиология


Микроорганизмы семейства Enterobacteriaceae

Бактерии Haemophilus influenzae

Гемофильная палочка на кровяном агаре

Патоген бактерия
Haemophilus influenzae на шоколадном агаре

Гемофильная палочка микробиология

Шигелла сальмонелла микробы

Гемофильная палочка микроскопия

Гемолиз стафилококк ауреус

Гемофильная инфекция возбудитель

Пневмококк, гемофильная палочка

Гемофильная палочка микробиология

Палочка Фридлендера Klebsiella